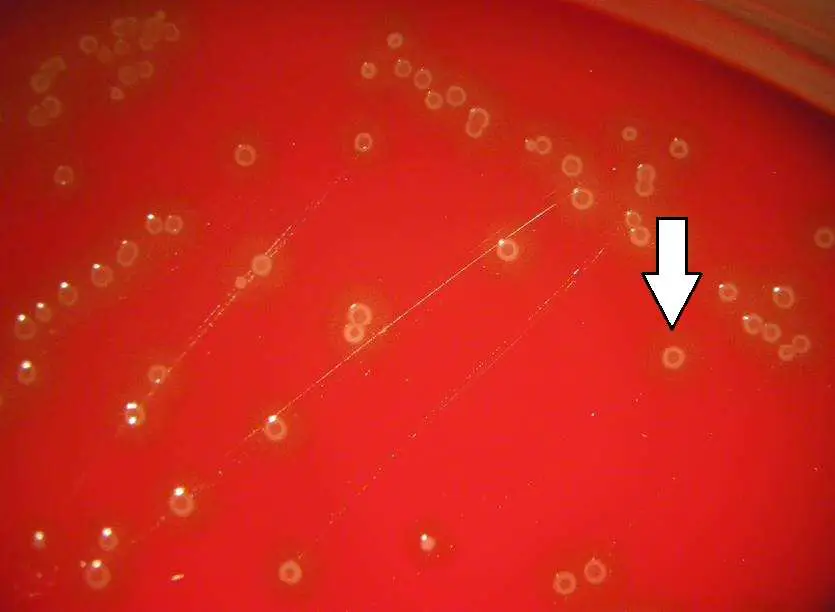
圖片

108年:(醫檢)微生(1)
依圖中之菌落特 徵(約 72 hrs )可能是下列何種菌?
AStaphylococcus aureus
BStreptococcus agalactiae
CStreptococcus pneumoniae
DStreptococcus pyogenes
詳細解析
本題觀念:
本題考細菌**菌落特徵(colony morphology)**的辨識,重點在於 Streptococcus pneumoniae(肺炎鏈球菌)在血液瓊脂(blood agar)上培養約 72 小時後出現的典型「製圖員菌落(draughtsman colony)」形態,以及其自溶(autolysis)特性。
影像分析:
圖為血液瓊脂(blood agar)平板,顯示以下特徵:
- 菌落大小:極微小,直徑約 0.5–1 mm,散布於平板上
- 菌落外觀:半透明(translucent)、灰白色(grey-white),表面隱約呈現中央凹陷、邊緣隆起的「製圖員外形(draughtsman/carrom coin appearance)」
- 白色箭頭指向典型的小型菌落,強調其特殊的中央凹陷形態
- 溶血帶:菌落周圍可見**α-溶血(alpha-hemolysis)**帶(血液瓊脂呈現淡綠色/棕綠色環帶),與 beta-溶血的完全透明帶不同
- 培養時間:約 72 小時,菌落已進行部分自溶,呈現典型的圓盤狀中央凹陷形態
此圖像特徵(小型半透明菌落、中央凹陷、α-溶血、72 小時呈現)高度符合 Streptococcus pneumoniae 的鑑定特徵。
選項分析
**(
...(解析預覽)...

升級 VIP 解鎖圖文解析